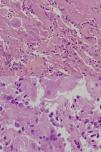

Los gangliocitomas intraselares son entidades poco frecuentes que en raras ocasiones pueden encontrarse asociados a adenomas funcionantes.
Caso clínicoMujer de 49 años estudiada por acromegalia, con lesión selar que se reseca por vía transesfenoidal endoscópica. El resultado histopatológico es de gangliocitoma con adenoma somatotrófico asociado.
DiscusiónEncontramos descritos en la literatura 85 casos de gangliocitomas intraselares asociados con adenomas hipofisarios funcionantes, de los cuales podemos distinguir: 50 productores de hormona de crecimiento (GH) (59%), 15 mixtos (productores de GH y prolactina) (17%), 11 productores de prolactina (13%), 7 productores de hormona adrenocorticotropa (ACTH) (8%) y 2 productores de hormona liberadora de corticotropina (CRH) (2%).
ConclusionesEn estas entidades es más común la asociación a secreción de GH y la presentación en mujeres de edad media. El diagnóstico es histopatológico. Es importante el conocimiento de esta entidad, por la posible limitación de respuesta terapéutica en la resección incompleta.
Intrasellar gangliocytomas are uncommon entities which, unusually, may be found in association with hormone-releasing pituitary adenomas.
Case reportThe patient was a 49-year-old female who presented a sellar lesion with associated acromegaly. A trans-sphenoidal tumour was removed, with no medical improvement. Histopathological analysis revealed a gangliocytoma with an associated somatotroph adenoma.
DiscussionWe found 85 cases of intrasellar gangliocytomas with associated hormone-releasing pituitary adenomas reported in the literature, with the following distribution: 50 growth hormone-releasing (GH) cases (59%), 15 mixed (GH and prolactin-releasing) cases (17%), 11 prolactin-releasing cases (13%), 7 adrenocorticotropic hormone-releasing (ACTH) cases (8%) and 2 corticotropin hormone-releasing (CRH) cases (2%).
ConclusionsMixed gangliocytomas-adenomas are uncommon entities. Association with growth hormone-releasing cases is more frequent and the most common presentation is among middle-aged females. Diagnosis is histopathological. Identification of this entity is important because it may lead to a limitation in therapeutic response in incomplete resections.
Artículo

Si es la primera vez que accede a la web puede obtener sus claves de acceso poniéndose en contacto con Elsevier España en suscripciones@elsevier.com o a través de su teléfono de Atención al Cliente 902 88 87 40 si llama desde territorio español o del +34 932 418 800 (de 9 a 18h., GMT + 1) si lo hace desde el extranjero.
Si ya tiene sus datos de acceso, clique aquí.
Si olvidó su clave de acceso puede recuperarla clicando aquí y seleccionando la opción "He olvidado mi contraseña".